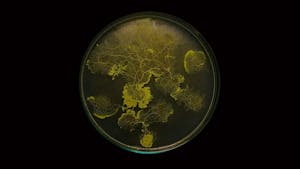
Réseaux-mondes

Réseaux-mondes
En compagnie de Marie-Ange Brayer, cheffe du service design et prospective industrielle
Visite
2 mars 2022
La réservation est fermée
Exposition collective, « Réseaux-mondes » réunit une soixantaine d’artistes, architectes et designers interrogeant la place du réseau dans nos sociétés innervées par les réseaux sociaux et la dématérialisation même du réseau. Plus que jamais, à l’ère d’Internet et de ce grand « réseau des réseaux », le réseau est au cœur des mutations technologiques et des enjeux sociétaux : surveillance, atomisation de l’individu, acteur-réseau… L’exposition aborde également le premier réseau, celui du vivant, qui relie les espèces entre elles.